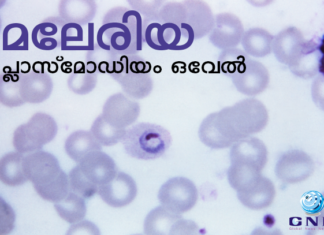
അപൂര്വ്വ മലേരിയ രോഗാണുവിനെ കേരളത്തില് ആദ്യമായി കണ്ടെത്തി

അയർലണ്ടിൽ വീണ്ടും മങ്കിപോക്സ് സ്ഥിരീകരിച്ചു
അയർലണ്ടിൽ ഒരാള്ക്ക് കൂടി മങ്കി പോക്സ് സ്ഥിരീകരിച്ചു. യു.കെയിലും യൂറോപ്പിലും രോഗം പടര്ന്ന സാഹചര്യത്തില് അയര്ലണ്ടില് ഇത് അപ്രതീക്ഷിതമല്ലെന്നും രോഗം ബാധിച്ച രണ്ട് പേരും ആരൊക്കെയായി സമ്പര്ക്കം പുലര്ത്തി എന്നതടക്കം കൃത്യമായി നിരീക്ഷണം...
ഇന്ത്യയിൽ കോവിഡ് കേസുകൾ വർധിക്കുന്നു; 39 കോവിഡ് മരണങ്ങള് സ്ഥിരീകരിച്ചു
ന്യൂഡല്ഹി: രാജ്യത്തെ പ്രതിദിന കോവിഡ് കേസുകളിലെ വര്ധനവ് തുടരുന്നു. കഴിഞ്ഞ 24 മണിക്കൂറിനിടെ 3303 കോവിഡ് കേസുകളാണ് റിപ്പോര്ട്ട് ചെയ്തത്. 46 ദിവസത്തിന് ശേഷമാണ് പ്രതിദിന കോവിഡ് കേസുകള് 3000 കടന്നത്.
24 മണിക്കൂറിനിടെ...
കഴിഞ്ഞ 10 ദിവസത്തിനുള്ളിൽ ഹരിയാനയിലെ ചില്ലി ഗ്രാമത്തിൽ പനി ബാധിച്ചു എട്ട് കുട്ടികൾ...
കഴിഞ്ഞ 10 ദിവസത്തിനുള്ളിൽ ഹരിയാനയിലെ പൽവാൽ ജില്ലയിലെ ചില്ലി ഗ്രാമത്തിൽ പനി ബാധിച്ചു എട്ട് കുട്ടികൾ മരിച്ചു. ഡെങ്കിപ്പനി മൂലമാണ് മരണം സംഭവിച്ചതെന്ന് ഗ്രാമവാസികൾ അവകാശപ്പെടുന്നുണ്ടെങ്കിലും ആരോഗ്യവകുപ്പ് ഇതുവരെ കാരണം സ്ഥിരീകരിച്ചിട്ടില്ല.
ആരോഗ്യവകുപ്പ് ജാഗ്രത...
സംസ്ഥാനത്ത് ഇന്ന് 32,097 പേര്ക്ക് കോവിഡ്, 21,634 പേര് രോഗമുക്തി നേടി; ടെസ്റ്റ് പോസിറ്റിവിറ്റി...
തിരുവനന്തപുരം: കേരളത്തില് ഇന്ന് 32,097 പേര്ക്ക് കോവിഡ്-19 സ്ഥിരീകരിച്ചു. കഴിഞ്ഞ 24 മണിക്കൂറിനിടെ 1,74,307 സാമ്പിളുകളാണ് പരിശോധിച്ചത്. ടെസ്റ്റ് പോസിറ്റിവിറ്റി നിരക്ക് 18.41 ആണ്. ഇതുവരെ ആകെ 3,19,01,842 സാമ്പിളുകളാണ് പരിശോധിച്ചത്.
കഴിഞ്ഞ ദിവസങ്ങളിലുണ്ടായ...
കേരളത്തില് 809 പേര്ക്ക് കോവിഡ്-19 സ്ഥിരീകരിച്ചു; 1597 പേര് രോഗമുക്തി നേടി
തിരുവനന്തപുരം: കേരളത്തില് 809 പേര്ക്ക് കോവിഡ്-19 സ്ഥിരീകരിച്ചു. കഴിഞ്ഞ 24 മണിക്കൂറിനിടെ 18,467 സാമ്പിളുകളാണ് പരിശോധിച്ചത്. ഇന്ന് രോഗം സ്ഥിരീകരിച്ചവരില് സംസ്ഥാനത്തിന് പുറത്ത് നിന്നും വന്നവര് ആരുംതന്നെയില്ല. 769 പേര്ക്ക് സമ്പര്ക്കത്തിലൂടെയാണ് രോഗം...
വെണ്ടക്ക തൈരുകറി
പേരുകേട്ടാൽ ഇച്ചിരി പുളിക്കുമെങ്കിലും അൽപം സ്പൈസിയായ കിടിലൻ ഒരു മസാലക്കറിതന്നെയാണിത്.
ഉണ്ടാക്കാനും വളരെ എളുപ്പം.
റെസിപി:
വെണ്ടക്ക മുക്കാലിഞ്ച് നീളത്തിൽ അരിഞ്ഞത് ഒരുകപ്പ്.പുളിയില്ലാത്ത തൈരു കട്ട്യില്ലാതെ ഉടച്ചത് കാൽക്കപ്പ്.പൊടിയായരിഞ്ഞ സവാള വലുത് ഒരെണ്ണം.പൊടിയായരിഞ്ഞ തക്കാളി വലുത് ഒരെണ്ണം.പച്ചമുളക്...
അപൂര്വ്വ മലേരിയ രോഗാണുവിനെ കേരളത്തില് ആദ്യമായി കണ്ടെത്തി
കണ്ണൂര്: ഇന്ത്യയില് അപൂര്വ്വമായി കാണപ്പെടുന്ന പ്രത്യേക മലേറിയ രോഗാണുവിനെ കേരളത്തില് കണ്ടെത്തി. സുഡാനില് നിന്നും വന്ന കണ്ണൂര് സ്വദേശിയുടെ രക്തപരിശോധനയില് ആണ് ഇത് കണ്ടെത്തിയത്. കണ്ണൂര് ജില്ലാ ആശുപത്രിയില് നടത്തിയ പരിശോധനയിലാണ് ജില്ലാ...
കേരളത്തില് 34,199 പേര്ക്ക് കോവിഡ്-19 സ്ഥിരീകരിച്ചു; 8193 പേര് രോഗമുക്തി നേടി
തിരുവനന്തപുരം: കേരളത്തില് 34,199 പേര്ക്ക് കോവിഡ്-19 സ്ഥിരീകരിച്ചു. കഴിഞ്ഞ 24 മണിക്കൂറിനിടെ 91,983 സാമ്പിളുകളാണ് പരിശോധിച്ചത്. ഇന്ന് രോഗം സ്ഥിരീകരിച്ചവരില് 125 പേര് സംസ്ഥാനത്തിന് പുറത്ത് നിന്നും വന്നവരാണ്. 33,195 പേര്ക്ക് സമ്പര്ക്കത്തിലൂടെയാണ്...
ആപ്പിൾ തൊലികളിൽ എന്തെല്ലാം ഗുണങ്ങൾ..
ദിവസവും ആപ്പിൾ കഴിച്ചാൽ ഡോക്ടറെ അകറ്റി നിർത്താം എന്നാണ് പൊതുവെ പറയാറുള്ളത്. എന്നാൽ ഇന്നത്തെ സ്ഥിതിഗതികൾ നേരെ മറിച്ചാണ്. വിപണികളിൽ നിന്നും ലഭിക്കുന്ന ആപ്പിളിന്റെ തൊലിയിൽ കീടനാശിനിയും മെഴുക്കുകളുമെല്ലാം ഗണ്യമായി ഉപയോഗിക്കുന്നുണ്ട് എന്ന...
ദിവസവും അച്ചാറ് കഴിച്ചാൽ…
ഉച്ച ഭക്ഷണത്തിനോടൊപ്പം ഒരൽപം അച്ചാറ് കൂടെ കരുതാത്തവരായിട്ട് ആരാണുള്ളത് അല്ലെ. മാങ്ങാ മുറിച്ച് ആഴ്ചകളോളം ഉപ്പിലിട്ട് ഒടുവിൽ അതിലേക്ക് മുളകരച്ച് ചേർത്ത് കുറച്ച് കടുകും വിനാഗിരിയും ചേർത്ത് കൂട്ടിക്കുഴച്ച് കുറച്ച് ദിവസം മൂടി...